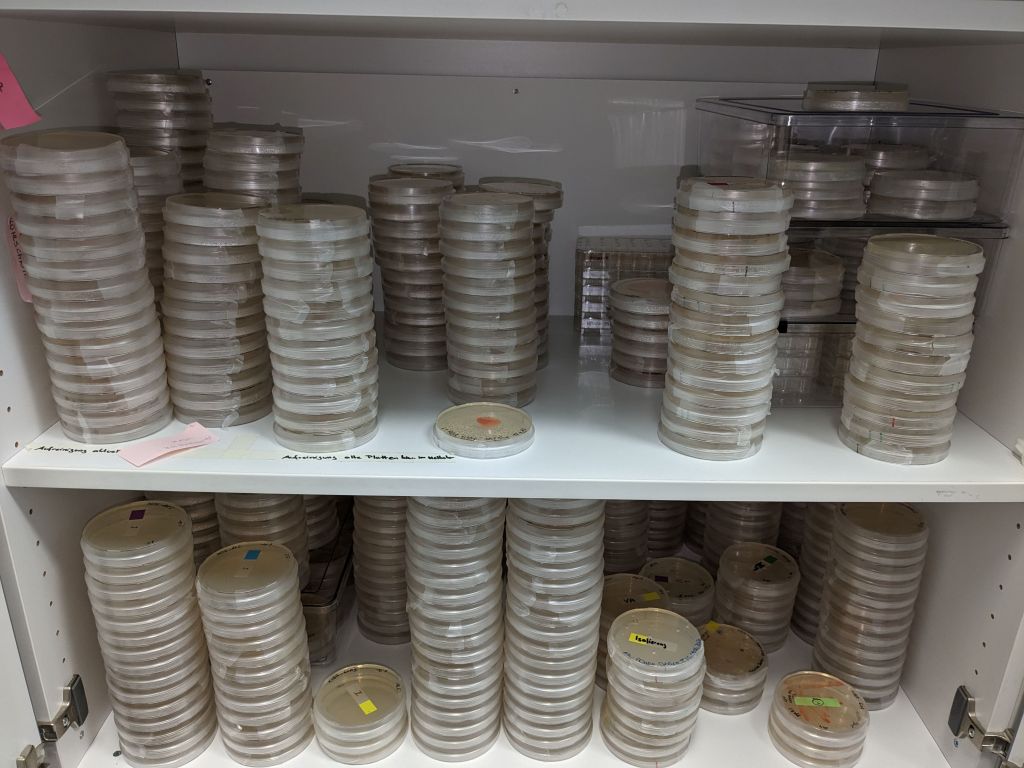
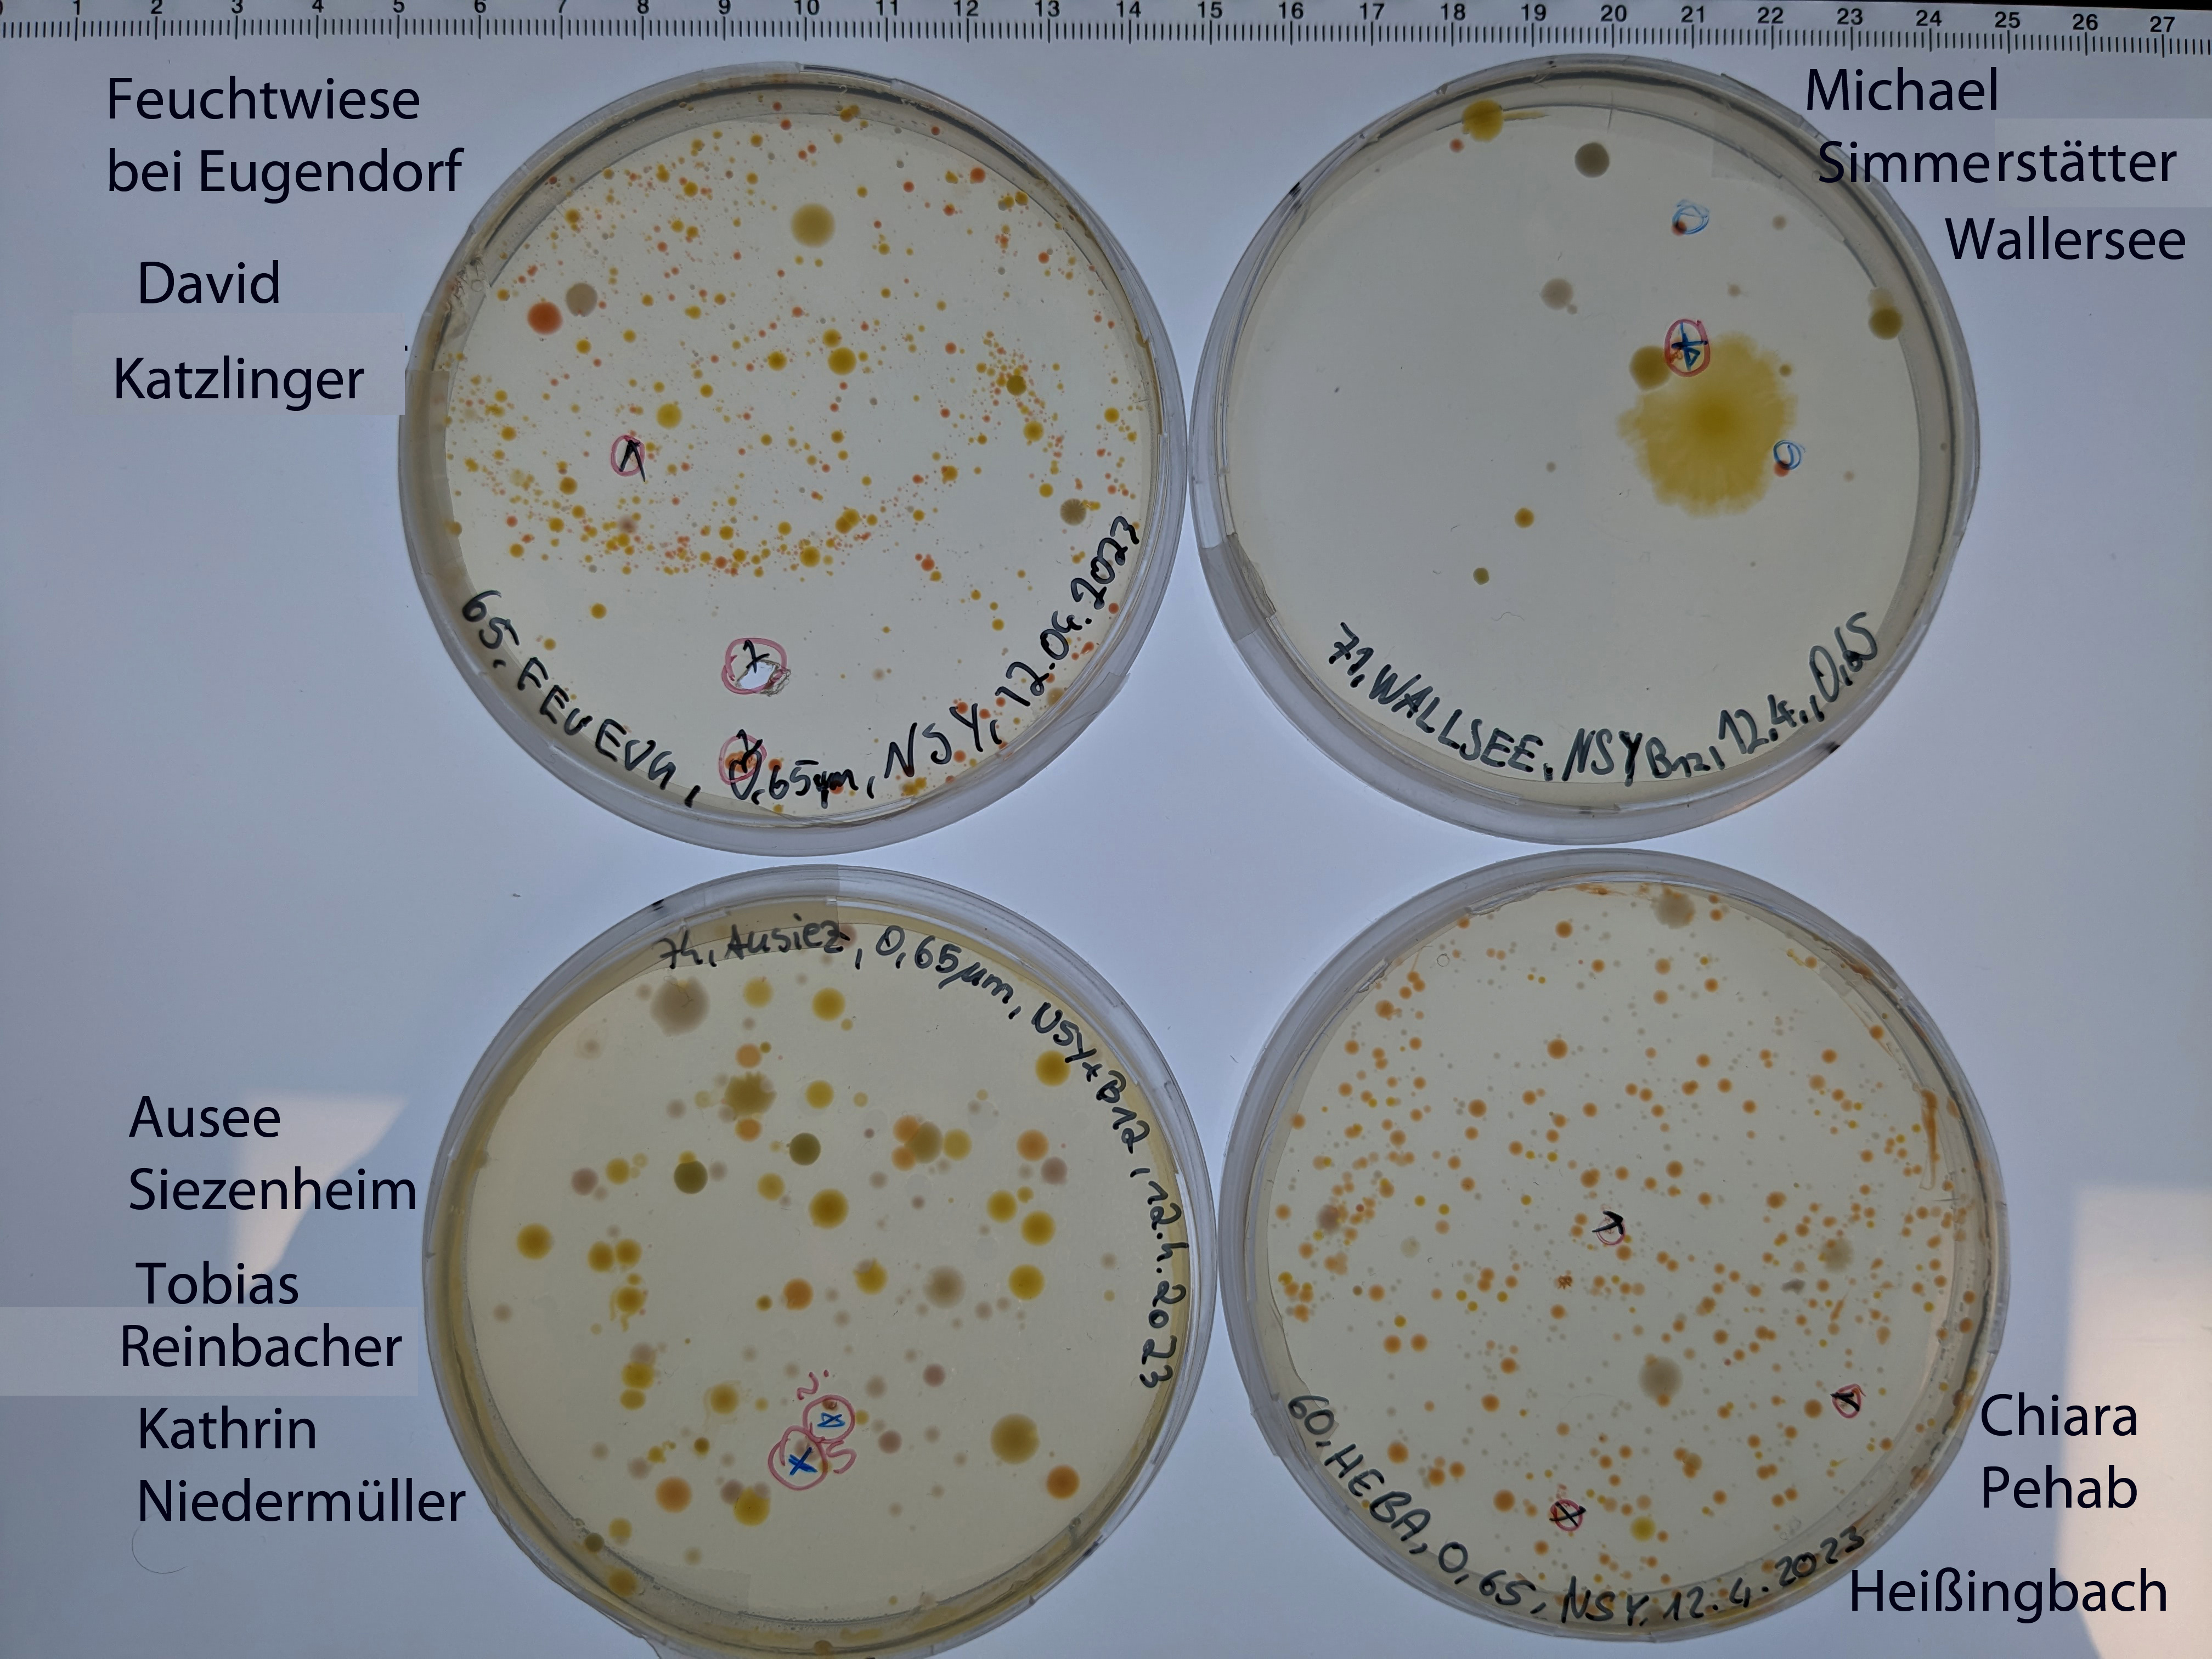
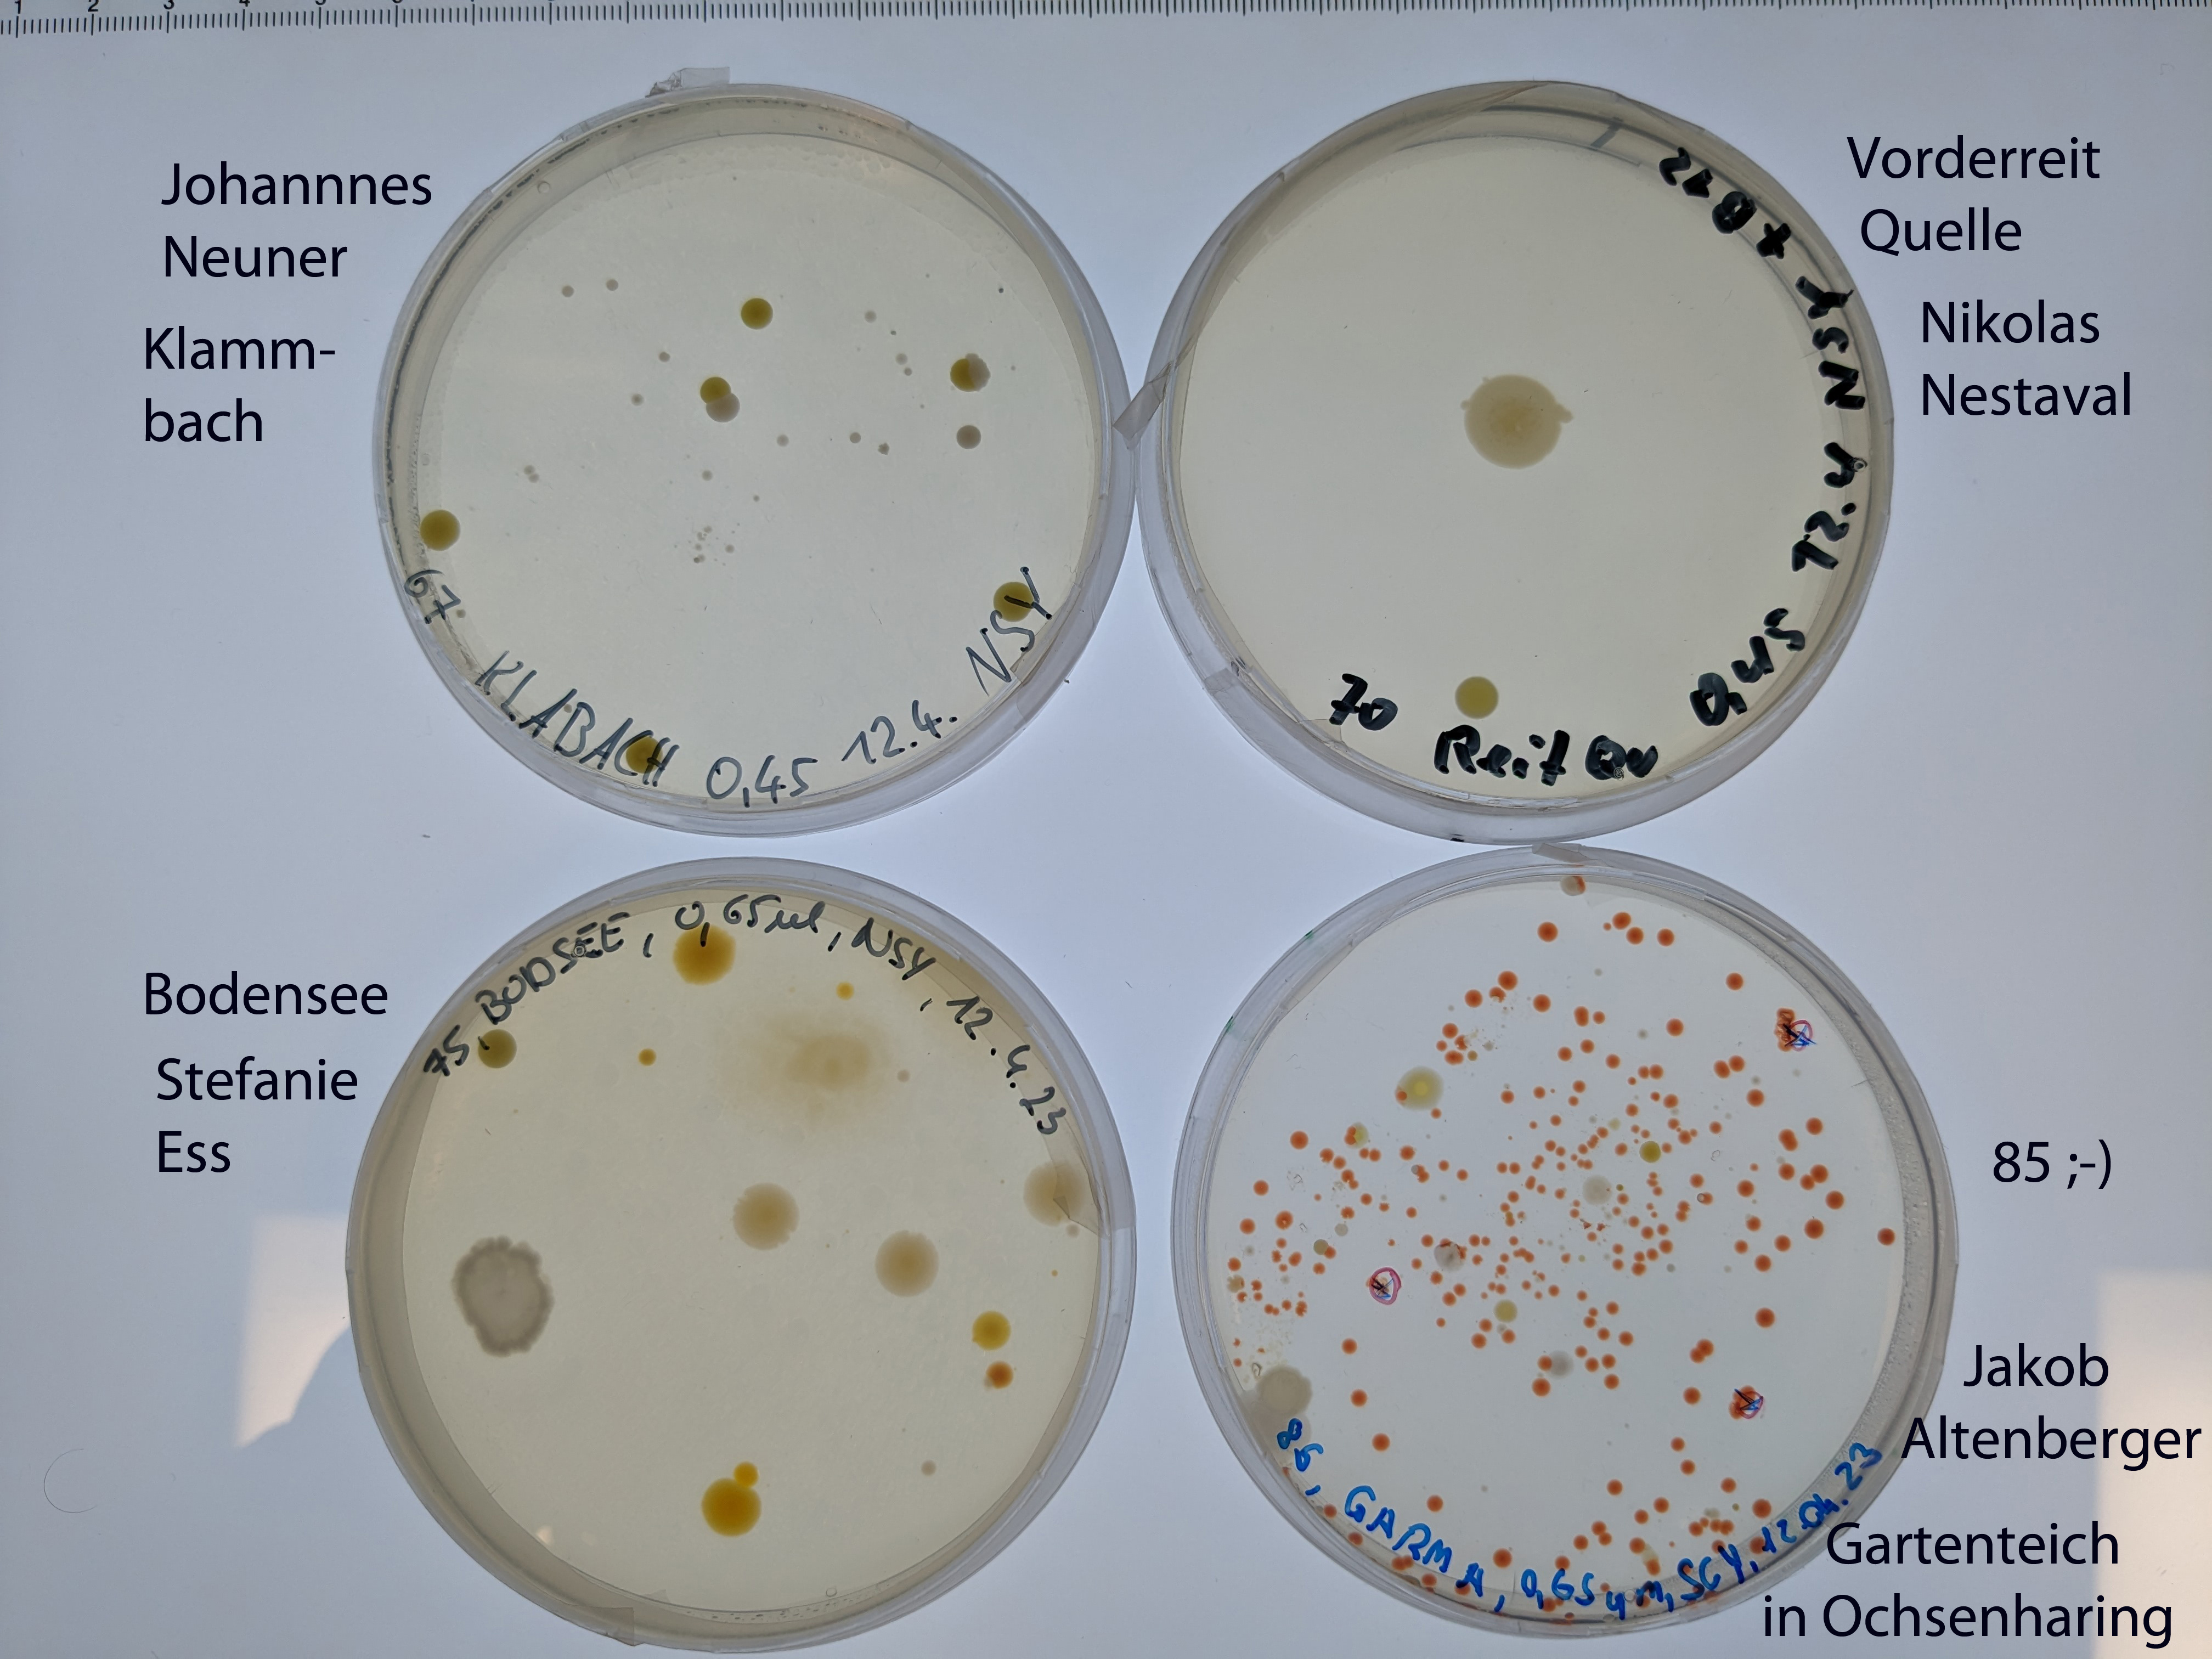

3UM (2022/2023) mit Stefanie Ess und Edith Oberkofler

1. Workshop
Ende März waren wir (Alexandra, Johanna, Stefan und Sabrina) an der Höheren Bundeslehranstalt für Landwirtschaft in Ursprung bei der 3.Klasse der Fachrichtung Umwelt- und Ressourcenmanagement und ihrer Biologielehrerin Stefanie Ess zu Gast. zum gesamten Beitrag

2. Workshop

Nach den Osterferien haben wir uns wieder zur HBLA Ursprung aufgemacht. Diesmal waren Martin, der Projektleiter höchstpersönlich 😉 , sowie Johanna und Stefan dabei. zum ganzen Beitrag
3. Agarplatten der Schüler/innen
So sehen die von den Schüler/innen mit ihren Wasserproben bearbeiteten Agarplatten nach einer guten Woche aus. Auf manchen ist schon vielversprechendes ‚Aquirufa-Rot‘ zu sehen. Von einigen Agarplatten haben wir schon Kolonien heruntergepickt und in flüssiges Medium gegeben. Man kann dies an den Markierungen auf den Platten sehen. Manche Bakterien brauchen vielleicht noch etwas Zeit, das wird sich in den nächsten Tagen zeigen.
4. Der Weg zu den Aquirufa Kulturen
Von den Agarplatten haben wir uns die Kolonien rausgesucht, die das typische ‚Aquirufa-Rot‘ zeigen. Diese haben wir vorsichtig mit einem (sterilisierten 😉 ) Zahnstocher in flüssiges Medium gegeben (Platte links). Dort konnten sich die Bakterienzellen weiter vermehren. Wenn die Kultur das typische Rot aufwies, haben wir davon wieder ein wenig auf eine Agarplatte pipettiert und mit einer Impföse (das sind die langen Stäbe im Bild) verteilt.

Im Bild sieht man die Flüssigkulturen. Sie stehen auf einem Schüttler in kleinen Erlenmeyerkolben und werden leicht geschaukelt, damit die Bakterien genug Luft bzw. Sauerstoff zur Verfügung haben. Inzwischen haben wir eine ganze Menge davon und müssen aufpassen, dass wir noch den Überblick behalten 😉 .

Und so sieht unser Fach im Kasten mit den Kulturen auf Agarplatten aus. Es sind ebenfalls eine ganze Menge. Zur Aufreinigung wird jeweils eine Kolonie aus einer Agarplatte ausgestochen und in flüssiges Medium gegeben. Das wiederholt man vier Mal, um eine Reinkultur, also eine Bakterienkultur, die nur Zellen von einem einzigen Bakterienstamm enthält, zu bekommen.
Um zu erfahren, ob die erhaltenen Bakterienstämme wirklich zur Gattung Aquirufa gehören, wird ein kleiner Abschnitt der DNA sequenziert. Dazu machen wir erst eine PCR und schicken das erhaltene Material zu Eurofins nach Deutschland.

Inzwischen haben wir aus neun Gewässern von den Wasserproben der HBLA Ursprung Bakterienkulturen, die zur Gattung Aquirufa gehören. Bei einigen können wir schon eine Zuordung zu bekannten Arten machen, erstaunlicherweise beherbergen manche Gewässer sogar mehrere Arten. Um sicher zu wissen, ob auch neue Arten darunter sind, werden wir von einigen Bakterienstämmen das gesamte Genom sequenzieren lassen.

Und das sind die Gewässer, aus denen wir bis jetzt Aquirufa-Kulturen erhalten haben: Wallersee (WALLSEE-71, Michael Simmerstätter), Feuchtwiese bei Eugendorf (FEUEUG-65, David Katzlinger), Bacherl in Robingstraße (ROBBACH-80, Alexandra Brkovic), Hechtteich bei Gauesed (HETE-83, Katharina Strohbichler), Bartolo in Tarvis 🙂 (FLUTAR-84, Sophia Reichl), Kunstteich am Frieserhof (KTFRIE-69, Matthias Reiterer), Heißingbach (HEBA-60, Chiara Pehab), Gartenteich in Ochsenharing (GARMA-85, Jakob Altenberger), Bach in Grabensee (BAGRA-66, Raphael Klingbacher).
5. Praktikum von Sophia und Tobias

Im Zuge unseres 14-wöchigen Praktikums, absolvierten wir (Sophia und Tobias) 4 Wochen in Mondsee. Wir konnten Einblicke in das Arbeitsleben einer Forschungsgruppe gewinnen und sahen was mit unseren Wasserproben vom Workshop passierte. zum ganzen Beitrag
6. Bioinformatikworkshop
Heute waren Alexandra und Stefan in der HBLA Ursprung in der 4. Klasse Fachrichtung Umwelt- und Ressourcenmanagement und ihren Lehrerinnen Edith Oberkofler und Stefanie Ess zu Gast. zum ganzen Beitrag

7. Sommerprobenahme am Mondsee

Bei herrlichem Wetter haben wir unsere Sommerprobenahmen am Mondsee durchgeführt. Mit dabei waren unsere drei Praktikant/innen Hannah, Sophia und Thomas hier gehts zum Beitrag
8. Besuch in Mondsee
Die inzwischen zur 5UM aufgestiegene Klasse war im November 2024 bei uns im Forschungsinstitut in Mondsee zu Gast. Mit dabei waren die Lehrerinnen Edith Oberkofler und Stefanie Ess. Stefanie hatte ihren zwei Monate alten Nachwuchs mitgebracht, sicher wird die Kleine Mal eine berühmte Mikrobiologin 😊. An verschiedenen Stationen wurde das Institut vorgestellt und die Schülerinnen konnten mit unseren Aquirufa Kulturen auf Agarplatten malen. Zum Abschluß gab es noch eine Stärkung bevor es wieder zurück in die Schule ging. Dieser Vormittag bildete den Abschluss der Zusammenarbeit mit der sehr netten und engagierten Klasse. Jetzt sind wir gespannt, wann die gemeinsam entdeckten neuen Bakterienarten in einem wissenschaftlichen Artikel verewigt werden.












9. Kunstwerke auf Agarplatten
Und hier sind die Kunstwerke gemalt mit Aquirufa Bakterien auf Agarplatten. Sie sind sehr beeindruckend 🙂
10. Publikation erschienen

Wie freuen uns sehr, dass unsere zweite wissenschaftliche Publikation im Projekt online erschienen ist. Untersucht haben wir dabei vier Gewässer im Renaturierungsgebiet der Weitwörther Au im Hinblick auf unsere Gewässerbakterien. Wir haben dabei zwei neue Arten entdeckt…hier gehts zum Beitrag
11. Wissenschaftliche Publikation erschienen
Unsere 3. wissenschaftliche Publikation ist erschienen und hier online verfügbar. Ca. 130 Citizen Scientist haben dabei mitgewirkt. Sechs Schulklassen und weitere Citizen Scientists haben Wasserproben aus selbst gewählten Gewässern genommen…hier gehts zum Beitrag